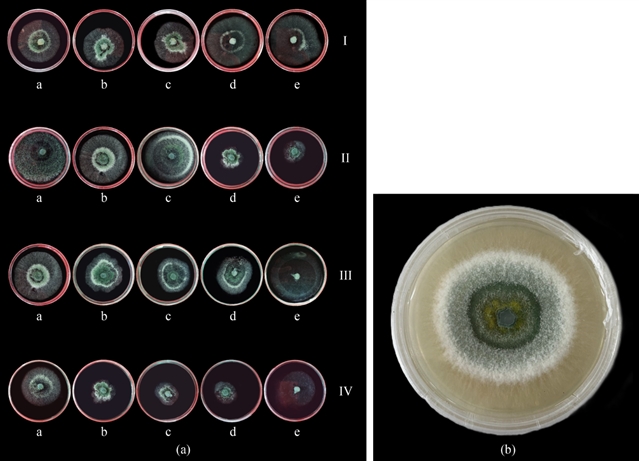
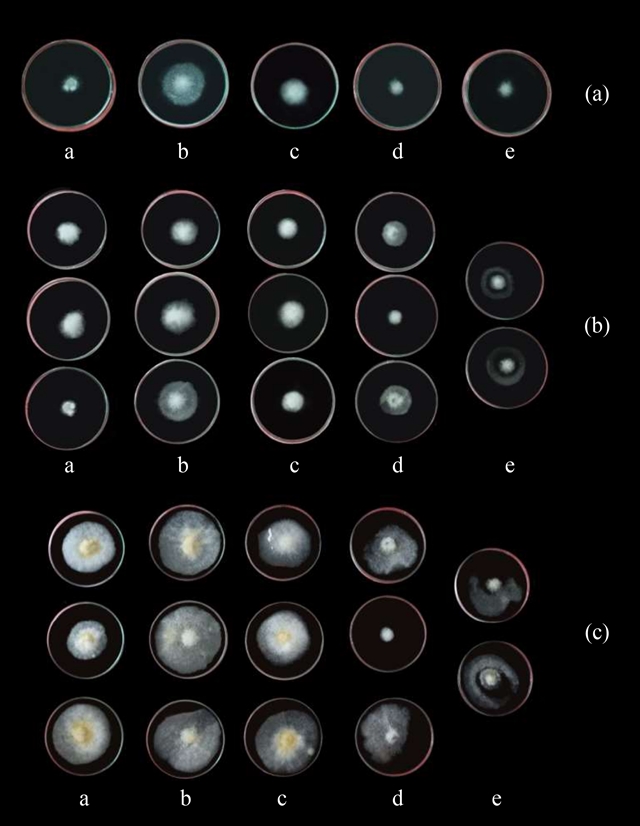

|
|
|
|
|
FASE 亮文解读丨印度拉夫里科技大学团队—生物炭作为木霉载体防治鹰嘴豆核盘菌的效果评价 |
|
|
论文标题:Evaluation of biochar as a Trichoderma carrier for managing Sclerotinia sclerotiorum in chickpea
期刊:Frontiers of Agricultural Science & Engineering
作者:Prashant PAVEEN, Vipul KUMAR, Prahlad MASURKAR, Devendra KUMAR, Amine ASSOUGUEM, Chandra Mohan MEHTA, Rachid LAHLALI
发表时间:15 Jun 2025
DOI:10.15302/J-FASE-2024598
微信链接:点击此处阅读微信文章

Jun 2025, Volume 12 Issue 2
· 第十五篇 ·
▎论文ID
Evaluation of biochar as a Trichoderma carrier for managing Sclerotinia sclerotiorum in chickpea
生物炭作为木霉载体防治鹰嘴豆核盘菌的效果评价
文章类型:Research Article
发表年份:2025年
第一作者:Prashant PAVEEN
通讯作者:Vipul KUMAR, Rachid LAHLALI
Email: vipul.19845@lpu.co.in, rlahlali@enameknes.ac.ma
作者单位:印度拉夫里科技大学农业学院;摩洛哥梅克内斯国立农业学院植物保护与环境学部
Cite this article :
Prashant PAVEEN, Vipul KUMAR, Prahlad MASURKAR, Devendra KUMAR, Amine ASSOUGUEM, Chandra Mohan MEHTA, Rachid LAHLALI. Evaluation of biochar as a Trichoderma carrier for managing Sclerotinia sclerotiorum in chickpea. Front. Agr. Sci. Eng., 2025, 12(2): 391–405 https://doi.org/10.15302/J-FASE-2024598
· 文 章 摘 要 ·
生物炭的大孔隙可为微生物生长提供适宜的生境,其高碳含量可作为有益微生物的能量来源。本研究评估了生物炭作为木霉载体在防治鹰嘴豆核盘菌病中的潜力。施用生物炭可使植株病害严重度降低36.5%,根质量增加23.3%。为此,研究测试了三种生物炭 (小麦秸秆、厨余有机废物、硬木) 与木霉的协同作用,分析了其有机碳、全氮、磷、钾、镁、钙含量,以及pH值和灰分含量等指标。接种后6周内,监测了不同目数 (250, 150, 75, 45 μm) 生物炭载体上的木霉种群动态。结果显示,150 μm目数的硬木生物炭上木霉种群数量最高,6周后可达33.5×105 CFU·g-¹;与其他类型生物炭相比,硬木生物炭的病害抑制效果最佳。本研究揭示了生物炭在促进植株生长和病害防治中的双重作用,为农业生产中生物炭应用的标准化提供了参考。
· 文 章 亮 点 ·
1. 硬木生物炭可维持最高的木霉种群数量并实现最佳病害抑制效果。
2. 硬木生物炭能降低植株病害严重度,增加植株根质量。
3. 最有效的制剂为4%硬木生物炭 (过100目筛)。
4. 该制剂可显著抑制病害并促进植株生长。
· Graphical abstract ·

· 研 究 内 容 ·
▎引言
鹰嘴豆作为印度重要的豆类作物,占全球产量的70%,2021–2022年产量达1400万吨,在粮食安全和经济中扮演关键角色。然而,由核盘菌 (Sclerotinia sclerotiorum) 引发的白霉病严重威胁鹰嘴豆的生产,该土传病害在适宜条件下可导致超50%的鹰嘴豆减产。传统防治手段存在局限性,因此探索环保型生物防治策略至关重要。
生物炭因具有多孔结构、高碳含量和保水的特性,可作为微生物载体并抑制病原菌。木霉 (Trichoderma) 具有多种对抗植物病原菌的机制,包括竞争营养、分泌抗菌物质以及产生抗真菌化合物,此外,还能诱导植物产生系统抗性,激活其对病原菌的防御机制,是重要的生防菌。尽管二者在农业中的应用已有研究,但生物炭作为木霉载体防治鹰嘴豆菌核病的具体效果,尤其是对于不同类型生物炭在维持木霉种群、促进植物生长方面的特性比较,仍有待深入探索与研究。本研究旨在评估生物炭作为木霉载体的潜力,明确其对核盘菌的抑制及促生效果,为可持续农业提供依据。
▎研究方法
研究从健康鹰嘴豆根际土壤中分离出木霉,通过系列稀释法和玫瑰红钠琼脂培养基纯化获得纯培养物。生物炭制备选取硬木、麦秆、厨余三种原料,经400 ℃限氧热解后粉碎过筛 (250, 150, 75, 45 μm),测定其pH值、有机碳、氮磷钾等养分含量及木质素、纤维素等成分。
通过马铃薯葡萄糖琼脂 (PDA) 培养基添加不同浓度 (1%–5%) 和粒径的生物炭,观察木霉和核盘菌的生长情况。田间试验采用随机区组设计,设置了8个处理 (含单一生物炭、生物炭+木霉、单一木霉及对照),评估鹰嘴豆的株高、根质量、叶片酚类物质含量及病害发生率。数据通过SPSS和R软件进行方差分析。
▎结果
1. 生物炭特性
不同原料生物炭的理化性质差异显著 (表1、表2)。硬木生物炭的木质素含量最高 (31.3%),是麦秆 (22.6%) 的1.38倍、厨余 (3.1%) 的10倍;纤维素含量 (34.5%) 同样居首位,较麦秆 (31.1%) 和厨余 (24.4%) 分别高出3.4%和10.1%;半纤维素含量 (27.4%) 也略高于麦秆 (22.9%) 和厨余 (24.7%)。高木质素和纤维素含量使硬木生物炭在热解后形成更稳定的芳香碳结构,孔隙更发达,为微生物提供了优质的栖息环境。
从化学性质来看,硬木生物炭有机碳含量 (77.9%) 高于麦秆 (66.9%) 和厨余 (71.7%),为微生物提供了更充足的碳源;pH值 (7.8) 接近中性,相比麦秆 (7.4) 和厨余 (8.2) 更利于真菌生长;灰分含量 (1.38%) 最低,减少了因灰分过高可能导致的土壤碱化风险。此外,硬木生物炭的氮 (2.37%)、钾 (4.20%) 含量也高于其他两种,为植物和微生物提供了更丰富的养分。
表1 不同生物炭原料的纤维素、半纤维素含量及碳氮比

表2 不同来源生物炭的性质及组成:有机碳、氮、磷、钾、钙、镁含量及灰分测定

2. 生物炭对木霉的影响
三种生物炭均能支持的木霉生长,其中硬木生物炭表现最优 (表3)。接种后1周,所有来源的生物炭上木霉种群数量基本一致,到接种后2周,种群数量均翻了一倍。至接种后6周,硬木生物炭上的木霉种群数量最高,达33.5×105 CFU·g-¹,厨余生物炭紧随其后。
表3 接种后2周、6周和10周的真菌种群平均数量

3. 木霉与核盘菌对生物炭的响应对比分析
(1) 不同浓度和粒径生物炭对木霉生长的影响
进一步分析粒径和浓度的影响 (图1, 图2):150 μm粒径的硬木生物炭在1%浓度时木霉生长最旺盛,菌落直径达最大值;250 μm粒径次之,45 μm粒径因孔隙过小抑制木霉扩散,生长最弱。浓度方面,1%–3%浓度的生物炭对木霉有促进作用,4%浓度时生长略降,5%浓度则显著抑制。这表明随着生物炭浓度的增加,不同粒径生物炭上木霉的生长量均下降。
图1 (a) 不同粒径生物炭与木霉组合的木霉生长情况;(b) 培养48小时后木霉对照生长情况。

图2 不同浓度及粒径生物炭下的木霉生长情况。
(2) 不同浓度和粒径生物炭对核盘菌生长的影响
硬木生物炭对核盘菌的抑制效果随浓度升高显著增强 (图3)。4%和5%浓度的生物炭对核盘菌的抑制效果最显著。需注意的是,原料类型对生物炭性质的影响可能比热解温度更大。因此,本研究中150 μm 粒径、4%和5%浓度的硬木生物炭对核盘菌生长有明显抑制作用。
图3 150 μm硬木生物炭不同浓度下核盘菌的生长情况。
4. 田间效果
(1) 株高和根重
硬木生物炭及其与木霉的组合显著提高了鹰嘴豆的株高和根干重 (表4)。硬木生物炭单施 (T1) 和硬木生物炭+木霉 (T4) 处理的根干重最高,分别为4.82 g和4.63 g,株高也呈现类似趋势。这些发现支持了以下假设:生物炭 (尤其是硬木生物炭) 及其与木霉的组合可促进植物生长,包括增加株高和根质量。T1和T4处理中观察到的根干重增加与已有报道中木霉对植物生长的促进作用及对根系结构的影响一致。
表4 田间种植鹰嘴豆的株高、根质量、病害发生率及总酚含量

(2) 总酚含量
酚类化合物是植物对逆境 (包括病原菌侵染) 防御反应的重要指标。本研究中,叶片中的酚类物质含量在T4处理中最高 (480 μg·g-¹没食子酸当量),而对照的平均酚含量为408 μg·g-¹没食子酸当量。酚浓度的增加表明,生物炭与木霉的组合不仅能抑制病原菌发育,还能增强植物的防御机制,使其更能耐受逆境。
(3) 发病率
病害发生率方面,T4 (硬木生物炭+木霉) 处理的抑制效果最佳,发病率最低,为44.8%。此外,该组合处理的植株酚含量也高于其他处理。酚含量的升高表明,硬木生物炭与木霉的组合可能诱导植物发生生化改变,进而增强其防御机制,显著抑制核盘菌的发展。
· 结 论 ·
本研究证实,硬木生物炭可作为高效木霉载体,显著抑制鹰嘴豆菌核病并促进植株生长。最优组合为4%浓度、150 μm粒径的硬木生物炭+木霉,其病害发生率降低至44.8%,根质量提升了23.3%,叶片酚类物质含量增加17.6%。这些结果表明,硬木生物炭作为一种双重功能土壤改良剂,在综合病害管理策略中具有巨大潜力,既能抑制病害,又能促进微生物生长。在农业实践中,建议采用最佳浓度和粒径的硬木生物炭,以最大化其在病害防治和植物生长促进中的效能。具体而言,4%浓度的硬木生物炭可作为防治鹰嘴豆核盘菌茎腐病的标准方案,并有望应用于其他作物。
《前沿》系列英文学术期刊
由教育部主管、高等教育出版社主办的《前沿》(Frontiers)系列英文学术期刊,于2006年正式创刊,以网络版和印刷版向全球发行。系列期刊包括基础科学、生命科学、工程技术和人文社会科学四个主题,是我国覆盖学科最广泛的英文学术期刊群,其中12种被SCI收录,其他也被A&HCI、Ei、MEDLINE或相应学科国际权威检索系统收录,具有一定的国际学术影响力。系列期刊采用在线优先出版方式,保证文章以最快速度发表。
中国学术前沿期刊网
http://journal.hep.com.cn

特别声明:本文转载仅仅是出于传播信息的需要,并不意味着代表本网站观点或证实其内容的真实性;如其他媒体、网站或个人从本网站转载使用,须保留本网站注明的“来源”,并自负版权等法律责任;作者如果不希望被转载或者联系转载稿费等事宜,请与我们接洽。